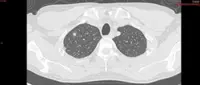
This dye lights up small, potentially cancerous growth on the lungs

KUALA LUMPUR: Many cases of lung cancer recorded among non-smokers are due to exposure to second-hand smoke (SHS), third-hand smoke (THS), or air pollution.
Dr Anand Sachithanandan, consultant cardiothoracic surgeon at Sunway Medical Centre, Sunway City, therefore, encouraged targeted lung cancer screenings to detect the disease earlier, which can be treated more effectively.
He said that lung cancer is no longer just a disease for male smokers, as most new cases now also involve non smokers, predominantly women, many of whom may be victims of chronic SHS exposure.
"Besides lung cancer, SHS and THS also contribute to other respiratory problems including asthma attacks, bronchitis, and Chronic Obstructive Pulmonary Disease (COPD) because cigarette smoke can affect lung tissue elasticity and cause inflammation in the respiratory passages.
"Additionally, smoking has been proven to be a risk factor for cardiovascular diseases such as Coronary Artery Disease (CAD) and hypertension, weakens the body's immune system, and leads to premature ageing," he said in a statement on Saturday (June 1).
Dr Anand, who is also Lung Cancer Network Malaysia (LCNM) chairman, said children and adolescents are more exposed to the dangers of SHS and THS as their immune systems are not yet fully developed.
"Exposure to SHS and THS at home, in public places such as eateries or workplaces, as well as in vehicles, can increase the likelihood of developing respiratory diseases in the long term," he said.
He added that according to the Global Adult Tobacco Survey (GATS), 77.6% of Malaysians surveyed reported being exposed to second-hand smoke in eateries.
Meanwhile, Dr Anand said the best screening test is through low-dose computed tomography (LDCT) scans, which are widely available throughout the country and that currently, the target individuals for screening tests are smokers and former smokers within certain age groups.
LDCT is a single- breath high-resolution non-contrasted chest scan that requires no insertion of needles, blood test or prior fasting.
Dr Anand noted that individuals with a family history of lung cancer should also consider getting checked, even if they do not smoke.
"Currently, we are exploring the use of artificial intelligence (AI) enabled chest X-rays as a prelude to LDCT screening as this is more affordable and widely accessible.”
"This is still under clinical investigation, as well as efforts to develop the potential use of blood tests as biomarkers to improve lung cancer detection outcomes during screening," he said, adding that lung cancer screening among non-smokers remains a challenge that needs to be addressed.
He said the public can also play a role by being considerate smokers, smoking only in Designated Smoking Areas (DSAs).
He underscored that the implementation of DSAs proposed by the Health Ministry is also a pragmatic approach that can be achieved if carefully planned and implemented, and strictly enforced. - Bernama
This is a paid advertorial article. Bernama assumes no responsibility for the content, accuracy and opinions carried in the article.